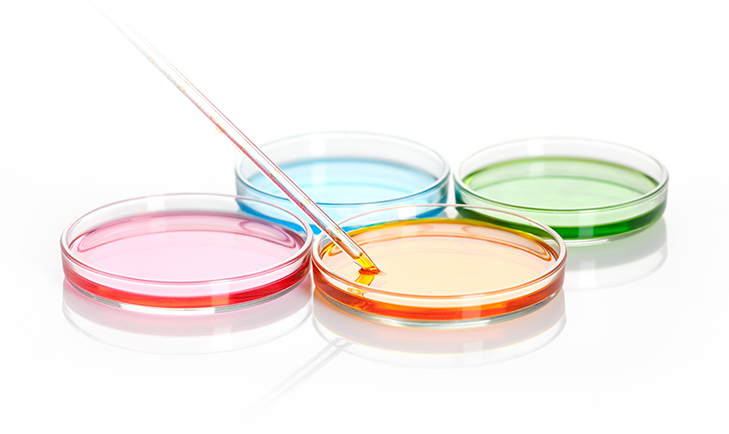

Preparat zawiera wszystkie witaminy z grupy B: tiaminę (wit. B1), ryboflawinę (wit. B2), niacynę (wit. B3), kwas pantotenowy (wit. B5), witaminę B6, biotynę (wit. B7), foliany (wit. B9, kwas foliowy), witaminę B12 oraz dwie substancje odżywcze – inozytol i cholinę.
Dla prawidłowego funkcjonowania organizmu konieczne są odpowiednie poziomy wszystkich witamin z grupy B, które są od siebie metabolicznie zależne. Oznacza to, że podczas syntetyzowania jednych witamin, potrzebna jest obecność innych. Preparat B-Komplex MSE dostarcza organizmowi 8 witamin z grupy B, cholinę oraz inozytol w wyjątkowo wysokich porcjach.
na prosty zwrot towaru
certyfikat SSL
płatności on-line
Suplement diety
B-Komplex MSE to zestaw 8 witamin z grupy B wspieranych przez cholinę i inozytol. Umożliwia utrzymywanie witamin na prawidłowym poziomie w komórkach.
Zawartość opakowania:
30 kapsułek – 25,5 g
1 kapsułka – 850 mg
Składniki:
dwuwinian choliny, substancja glazurująca: hydroksypropylometyloceluloza,
D-pantotenian wapnia, inozytol, amid kwasu nikotynowego, ryboflawina, substancja
wypełniająca: maltodekstryna, chlorowodorek tiaminy, chlorowodorek pirydoksyny,
substancja wypełniająca: celuloza mikrokrystaliczna, substancja przeciwzbrylająca:
sole magnezowe kwasów tłuszczowych, substancja przeciwzbrylająca: dwutlenek krzemu,
D-biotyna, sól glukozaminowa kwasu (6S)-5- metylotetrahydrofoliowego, kwas foliowy,
metylokobalamina.
Zalecana porcja dzienna: 1 kapsułka dziennie – rano, popijając wystarczającą ilością wody.
Skład zalecanej dziennej porcji:
Substancja | 1 kapsułka | *RWS |
---|---|---|
Cholina (Witamina B4) |
100 mg |
- |
Inozytol (Witamina B8) |
100 mg |
- |
Niacyna (Witamina B3) |
100 mg |
625,00% |
Kwas pantotenowy (Witamina B5) |
100 mg |
1.666,67% |
Ryboflawina (Witamina B2) |
50 mg |
3.571,43% |
Tiamina (Witamina B1) |
40 mg |
3.636,36% |
Witamina B6 |
1,4 mg |
100,00% |
Biotyna (Witamina B7) |
500 μg |
1.000,00% |
Kwas foliowy |
200 μg |
100,00% |
Kwas foliowy metylowany |
200 μg |
100,00% |
Metylokobalamina Witamina B12 |
100 μg |
4.000,00% |
*RWS - Referencyjna Wartość Spożycia
Nie należy przekraczać zalecanej porcji do spożycia w ciągu dnia. Suplement diety nie może być stosowany jako substytut (zamiennik) zróżnicowanej diety. Należy przestrzegać zdrowego trybu życia i zrównoważonego sposobu żywienia. Nie stosować w przypadku nadwrażliwości na składniki preparatu.
Warunki przechowywania:
Przechowywać poza zasięgiem małych dzieci, zamknięte, w temperaturze pokojowej, w
suchym miejscu.
Najlepiej spożyć przed końcem (miesiąc, rok) / Numer partii: patrz etykieta na spodzie.
Wyprodukowano przez: MSE Pharmazeutika GmbH, Dr. Franz Enzmann, Nehringstrasse 15,
D-61352 Bad Homburg (NIEMCY)
Dla: Mito-Pharma Sp. z o.o., ul. gen. Władysława Sikorskiego 22, 66-400 Gorzów
Wielkopolski (POLSKA), tel.: 095 736 50 50, email: biuro@mito-pharma.pl /
www.mito-pharma.pl
Kiedy warto stosować kompleks witamin z grupy B?
- Gdy chcesz przyczynić się do zmniejszenia uczucia zmęczenia oraz znużenia. (niacyna, kwas pantotenowy, ryboflawina, witamina B6, foliany, witamina B12)
- W celu utrzymania prawidłowego metabolizmu energetycznego. (niacyna, kwas pantotenowy, ryboflawina, tiamina, biotyna, witamina B6, B12)
- Dla utrzymania prawidłowego metabolizmu homocysteiny (cholina, witamina B6, foliany, witamina B12), funkcjonowania serca (tiamina) i produkcji czerwonych krwinek (witaminy B6 i B12).
- Kiedy chcesz wesprzeć ochronę antyoksydacyjną organizmu. (ryboflawina)
- Aby wspomóc prawidłowe funkcjonowanie układu nerwowego. (niacyna, ryboflawina, tiamina, witamina B6, witamina B12)










- Jeżeli marzysz o zdrowej skórze (ryboflawina, niacyna, biotyna) oraz o zdrowych włosach (biotyna).
- Gdy ważne jest dla Ciebie wsparcie układu odpornościowego. (witamina B6, foliany, witamina B12)
- Jeśli chcesz wesprzeć prawidłowy metabolizm żelaza (ryboflawina), białek (wit. B6), tłuszczów (cholina), glikogenu (wit. B6), a także gospodarkę hormonalną organizmu (witamina B6).
- W przypadku zwiększonego zapotrzebowania organizmu na witaminy z grupy B.
Dlaczego B-Komplex MSE?
- B-Komplex MSE to preparat zawierający kompletny zestaw witamin z grupy B o wzajemnie uzupełniającym się działaniu.
- B-Komplex MSE zawiera aktywną postać witaminy B12 – metylokobalaminę.
- Preparat stanowi dobre źródło folianów (witamina B9, kwas foliowy) oraz jego biologicznie aktywnej formy, czyli metylotetrehydrofolianu (5-MTHF).

- Cholina wspiera funkcjonowanie wątroby.
- B-Komplex MSE to produkt bezglutenowy, odpowiedni dla wegan, wegetarian i osób z nietolerancjami pokarmowymi.

B-Komplex MSE - jak stosować?
- Wystarczy Ci już 1 kapsułka dziennie.
- Preparat przyjmuj najlepiej rano, popijając wystarczającą ilością wody.

Co wchodzi w skład zestawu witamin B-Komplex MSE?
-
Preparat zawiera najważniejsze witaminy z grupy B w odpowiednio wysokich porcjach i formie.
Należą do nich:
tiamina (witamina B1), ryboflawina (witamina B2), niacyna (witamina B3, niacynamid), kwas pantotenowy (witamina B5), witamina B6, biotyna (witamina B7), foliany (witamina B9, kwas foliowy), witamina B12. W skład preparatu wchodzą również cholina oraz inozytol.
- Postać kompleksu witamin sprzyja bardzo dobremu przyswajaniu oraz skutecznemu wykorzystaniu substancji czynnych przez organizm.
- B-Komplex MSE to źródło aktywnych biologicznie form witaminy B12, folianów (kwasu foliowego, witaminy B9) oraz witaminy B6. Powyższy materiał został przygotowany na podstawie badań/ źródeł naukowych.
Nie stanowi zaleceń lekarskich bądź dietetycznych i ma charakter wyłącznie informacyjny.

Jakość i czystość B-komplex MSE
- Preparaty oferowane przez firmę Mito-Pharma® produkowane są w Niemczech w oparciu o 50 lat badań i praktyki dr. Franza Enzmanna z zachowaniem najwyższych standardów jakości GMP (zasada dobrej praktyki produkcyjnej). GMP gwarantuje ścisłą kontrolę od momentu zaopatrzenia w surowce, poprzez produkcję, pakowanie, aż do składowania i dystrybucji preparatu. Dzięki temu eliminowane są wszelkie zagrożenia dotyczące zanieczyszczenia preparatu obcymi substancjami chemicznymi, czy też szkodliwą mikroflorą.
- Preparat zawiera fizjologiczne substancje o możliwie najwyższym stopniu czystości w odpowiednio wysokich porcjach i formie.
- Mitoceutyki® powstają w laboratorium dr. Franza Enzmanna, w oparciu o najnowocześniejsze osiągnięcia naukowe i technologiczne, oraz spełniają najwyższe standardy jakościowe. W swoim składzie zawierają substancje o najwyższym stopniu czystości.
